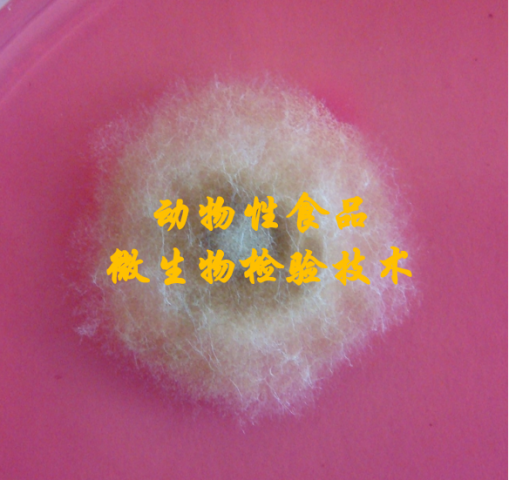

结果:
暂时没有选择过滤条件
共3门课程
-

开课(1)
-
开课(1)
-

开课(1)
